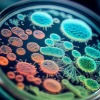

國立陽明交通大學口腔生物研究所
- 設立宗旨
成為頂尖口腔生物基礎醫學研究及人才培育中心,並與國際接軌。
- 教育目標
培育口腔生物研究領域之人才,學習實驗技術,培養獨立思辨,歸納分析及表達能力等研究技能,並具備國際觀。
研究領域

口腔癌病理
- 口腔癌致病分子病理與轉移之研究
- 口腔癌幹細胞及類器官之研究
- 非編碼RNA於口腔癌病理之角色
- 代謝重整於口腔癌癌化之探討
- 齒源癌類器官模型
- 精準口腔癌醫學
口腔微生物及牙周病學
- 單純疱疹病毒感染對口腔細胞的影響
- 牙周病致病機轉與系統性疾病關聯
- 飲食對口腔微生物生物膜影響之探討
- 牙周病與系統性疾病的相關性
- 口腔益生菌研究

再生牙醫學及口腔生醫材料
- 骨及唾液腺再生研究
- 電化學技術與植體表面改質
- 3D列印光聚合生物墨水開發

公共衛生及健康促進
- 流行病學
- 口腔健康促進防治
- 高齡牙醫學
- 咀嚼吞嚥及顳顎關節障礙病理分析

精準醫學及生物資訊
- 生物資訊分析
- 機器學習
- 基因體學
系所簡介
本所成立於民國82年2月,同年5月起招收牙醫、醫、理、農、工各科系畢業之學生,於民國91年成立博士班並開始招生。
本所師資陣容堅強,除了本校牙醫學院老師,也聘請中研院等研究機構生醫領域學有專精的兼任老師,期透過學經歷涵養俱佳及豐富的教學資源,以培育出更多優秀專業人材。
課程特色為:提升學術表達能力、多元化課程、精緻小班教學、研究生-指導老師制度、優渥獎助學金、海內外產學合作機會。
本所具優質的研究團隊與活絡的學術氣氛,本所亦定期邀請外賓和傑出校友進行學術討論與生涯規劃,並舉辦迎新、期末聚餐、實驗室安全教育訓練等,增進師生交流。